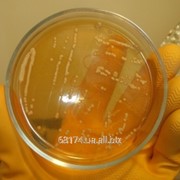

Бифидум Среда Оболенск

💣 👉🏻👉🏻👉🏻 ИНФОРМАЦИЯ ДОСТУПНА ЗДЕСЬ! КЛИКАЙ 👈🏻👈🏻👈🏻
Бифидум-среда Оболенск и другие питательные среды - лабпреп .ру
Бифидум-среда (Оболенск) - (О53-К) - Питательные среды сухие
Агар Бифидум Оболенск в Киеве (Среды питательные . . .
Среда бифидум оболенск инструкция
Микробиология агары, среды Оболенск, бульоны, сыворотки . . .
Питательные среды ФГУН ГНЦ ПМБ "Оболенск"
Бифидум среда (среда Блаурока) (Оболенск) - 990грн . . .
Ft-агар Оболенск И Другие Питательные Среды - Лабпреп .ру
Стафилококкагар Оболенск и другие питательные среды-лабпреп .ру
Питательные_среды_для_микробиологии_эпидемиологии
Бисептол Обезболивает
Таблетки Бипрол Аналог
Кломипрамин
Бифидум-среда Оболенск представляет собой мелкодисперсный, гигроскопичный, светочувствительный порошок светло-желтого цвета . Выпускается в полиэтиленовых банках по 250 г . 2 .1 . ПРИНЦИП ДЕЙСТВИЯ
Инструкция Бифидум среда 109 .21 kb Описание Набор реагентов для бактериологических исследований "Питательная среда для культивирования и выделения бифидобактерий сухая (Бифидум-среда)" по ТУ 9398-041-78095326-2008, 250г
Агар Бифидум Оболенск от 7627 .33 ₽ в Киеве . Компания ПЕТ, ООО на BizOrg .su, ID 15971460 .
Среда бифидум оболенск инструкция Бифидум-среда 0,25 кг Кат . № О53 Цена: 13 698 .00 rub Вы можете добавить товар в корзину, указав количество Производитель: Оболенск Страна: Россия
trio-medical .ru › product › mikrobiologiya-agary-sredy-pitatelnye-bulony-syvorotki-diagnostikumy-indikatory-3
Бифидум- среда (Оболенск) (Набор реагентов для бактериологических исследований «Питательная среда для культивирования и выделения бифидобактерий») Бордетелагар (Оболенск) (Набор реагентов для бактериологических исследований «Питательная среда для культивирования и выделения коклюшного микроба сухая») Бруцелла-агар (Оболенск) (0,250 кг)
td-himex .ru › laboratornoe-osnashchenie › mikrobiologiya › pitatelnye-sredy › pitatelnye-sredy-fgun-gnts-pmb-obolensk .html
Бифидум- среда . Питатательная среда для культивания и выделения бифидобактерий, сухая 0,25
Бифидум среда (среда Блаурока) (Оболенск) - 990грн, Україна, Київська область, КИЇВ . Бифидум среда (среда Блаурока) (Оболенск) - 990грн/кг, Бульон питательный сухой ГРМ (Оболенск) - 690грн/кг, Бульон питательный сухой (Углич . . .
«FT-агар Оболенск» предназначен для бактериологических исследований в санитарной и клинической микробиологии с целью выделения возбудителя туляремии из клинического материала и объектов внешней среды при диагностике инфекционных заболеваний «in vitro», а также для культивирования туляремийного микроба для научных работ . характеристика набора
Стафилококкагар Оболенск предназначен для выделения стафилококка из исследуемого материала . Представляет собой гигроскопичный мелкодисперсный порошок светло-желтого цвета . Состав: Панкреатический гидролизат рыбной муки, панкреатический гидролизат казеина, пептон ферментативный, дрожжевой экстракт, натрия хлорид, натрия гидрофосфат, агар .
www .kalugamed .ru › news › 1790
Среда №9 . Оболенск . 0,25 . Среда №9* Биомед . 0,25 . Среда №10 . Оболенск . 0,25 . Среда №10 . Биомед . 0,25 . Среда №11 . Оболенск . 0,25 . Среда №11* Биомед . 0,25 . Среда №12 Селенитовый бульон* Оболенск . 0,25 . Среда №12 Селенитовый бульон . Махачкала . 0,2-0,5 . Среда №13
Мальтофер Справочник Видаля
Менопур 75 В Наличии
Сиалор Спрей Отзывы
Таблетки Пантопразол
Фенистил Гель Аналоги Отзывы
Флюдитек При Ларинготрахеите
Фосфалюгель Крепит Или Слабит
Пульмикорт Побочные Действия У Детей Форум
Парацетамол 3 Месячному Ребенку
Юниэнзим Для Пищеварения
Пантокрин Или Элеутерококк Что Лучше
Пантенол Для Регенерации Кожи
Гербион Барановичи
Викасол Усолье
Рибоксин Авексима
Гексикон Лонгидаза
Расторопша Похудеть Отзывы
Цитрат Магния Нижний Новгород
Лориста Таблетки 25мг Цена
Ингаляции С Циклофероном Детям Отзывы
Риофлора Иммуно Нео Инструкция
Нак Контакты
Найз Уколы
Коэнзим Q10 Для Женщин После 30
Амоксициллин И Толперизон Совместимость
Инъектран 0 1 Мл 2мл N10
Температура После Превенара
Доктор Мом 150 Мл
Эспумизан 7 Лет
Сиалор Спрей 2
Стрепсилс Интенсив Противопоказания К Применению
При Заложенности Носа Тизин Или Оксифрин
Пимафуцин Свечи Цена Аптека Вита
Церукал При Рефлюксе
Фламакс Форте От Зубной Боли
Дексаметазон Уколы В Нос
Лактазар Сколько Давать
Флуконазол От Грибка Ушей
Метилурацил При Колите Кишечника Отзывы
Эспа Липон 600 Ампулы
Лекарство Ребагит Инструкция По Применению Цена Отзывы
Таблетки От Кашля На Основе Трав Renewal
Цефиксим При Гайморите Взрослым
Немозол Сыпь
Симбикорт Саратов
Рабепразол Побочные Эффекты Отзывы
Селмевит 30 Таблеток Отзывы
Итраконазол Таблетки Цена Аналоги Дешевые
Фестал Цена В Калининграде
Панадол Таблетки Цена Москва
Урсосан При Эзофагите Отзывы
Ци Клим Цена В Аптеках Екатеринбурга
Цена Таблеток Нобазит 500мг
Омепразол Инструкция Фото
Хлорпротиксен Отзывы Для Детей Аутистов
Холензим Отзывы Применения
Реамберин Отзывы Пациентов Принимавших
Конкор Как Выглядит Таблетка
Эваменол Применение
Престилол Применение
Кардиомагнил 100 Таблеток
Сорбифер Дурулес При Беременности 2 Триместр
Дилакса Ярославль
Лазолван При Коронавирусе Можно
Кветиапин Как Влияет На Давление
Аналоги Экоцистина Цена Отзывы
Гентамицина Сульфат Бетаметазон Клотримазол
Лапчатка Белая Екатеринбург
Аптеки Горздрав Лимфомиозот Отзывы
Клималанин Таблетки Цена
Цераксон 100 Мл
Селенцин Пептид Лосьон
Окситоцин Для Чего Его Применяют После Родов
Как Вскрыть Ампулу Мексидола
Аналоги Небидо По Действующему Веществу
Ротокан При Флюсе Инструкция По Применению
Перинева Побочные Эффекты У Женщин
Антибиотики Цефазолин Таблетки
Флебофа Побочные Действия Отзывы
Диротон Венгрия
Пиковит Сироп 150 Мл
Получение Нитрата Кальция Из Гидроксида Кальция
Кеппра Эффект Отмены
Милурит Отзывы Форум
Урсосан 250 Цена В Спб Аптека
Тенотен Ижевск
Метипред Цена Применение
Гексорал От Вирусов
Бронхипрет При Бронхите
Цефтриаксон Инструкция Таблетки Взрослым
Комплексные Соли Кальция
Сколько Стоит Валсартан 80 Мг
Гидроксид Железа Хлорид Цинка
Фенкарол 10 Мг Инструкция
Трава Спорыш Применение Фото Крупным
Препарат Цитиколин Показания К Применению Цена Отзывы
Парацетамол Инструкция 9
Пимафуцин Мазь Показания К Применению
Зодак Цена В Москве В Аптеках
Vsustav Ru Сайт Заказать Хронотрон
Бифидум Среда Оболенск